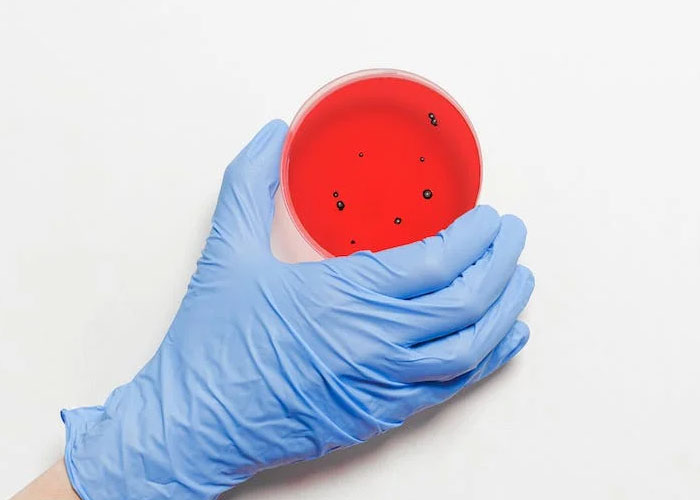
A Netizen Wanted To Hear Some Creepy Facts About Human Nature, The Internet Provided 40 Chilling Answers

A Netizen Wanted To Hear Some Creepy Facts About Human Nature, The Internet Provided 40 Chilling Answers
Being human means sometimes being deeply ignorant about how anything works. As a child, you may have thought this was strange and, obviously, you needed to know everything, but a part of adulthood is realizing that, often, not knowing is better.
Regardless, one person decided to indulge in the more eerie side of life and asked the internet for all the creepy facts about human existence. They got what they asked for, so scroll through, if you dare, and be sure to upvote your favorite facts and comment any you know that were mentioned below.
This post may include affiliate links.
 The call of the void. This occurs when humans are on high places, like rooftops or cliffs, and get the urge to jump. It’s actually pretty common.
The call of the void. This occurs when humans are on high places, like rooftops or cliffs, and get the urge to jump. It’s actually pretty common.
Everybody has a self-destructive instinct. It just manifests in different ways.
 I don't know if this is fact, but apparently humans have an instinct to know when they're being stared at by someone, so when you feel like you're being looked at you're probably right.
I don't know if this is fact, but apparently humans have an instinct to know when they're being stared at by someone, so when you feel like you're being looked at you're probably right.
It's true. And really weird. The best guess I have is that when someone or something is concentrating on you they stop breathing or change their breathing, and you hear the change in sound and it sets off an alarm. Some animals have the same spooky sense.
Despite the fact that many of these ideas are presented as downright creepy, humans do have a weird psychological desire to artificially feel this feeling. Maybe it’s a surge of adrenaline or a sort of heightened state, but this sort of internet content and the entire horror genre all revolve around it.
For example, sometimes our hair will stand on end and we’ll break out in goosebumps when we feel, often unknowingly, unsettled. A horror franchise of the same name exists probably for this reason. In humans, there is some speculation that we have this reaction when our bodies are being moved without our control, such as an earthquake.
 That pretty much everyone has the capacity for extreme evil given the right circumstances.
That pretty much everyone has the capacity for extreme evil given the right circumstances.
 Most people that die due to hypothermia get naked before dying.
This is because, blood stops flowing to your extremities, so you don't lose body heat. Just before death, the brain kinda "gives out" and allows blood flow to return to normal. This sends warm blood to your cold limbs, making you feel very hot and sweaty, so you strip.
Before this was understood, people that had died of hypothermia were believed to have been sexually assaulted because they were fully naked
Most people that die due to hypothermia get naked before dying.
This is because, blood stops flowing to your extremities, so you don't lose body heat. Just before death, the brain kinda "gives out" and allows blood flow to return to normal. This sends warm blood to your cold limbs, making you feel very hot and sweaty, so you strip.
Before this was understood, people that had died of hypothermia were believed to have been sexually assaulted because they were fully naked
 One of my favorite aspects about human nature is how there are things in nature that we are the best at. Sure we’re not the fastest, strongest, or most agile. But out of everything in the animal kingdom, we can run the longest.
Humans are adapted to do what very few animals can do, which is run for extended periods of time. Here’s where it gets creepy, I saw it explained like this:
Imagine you’re a gazelle on the plains of Africa early on in human history. You see some hairless apes running towards you, but f**k are they kind of slow. So your instincts kick in and you sprint away. Once they’re out of sight you relax and go back to eating grass or whatever you’re doing. But f**k, there they are again, running slowly towards you. How’d they figure out where you went?
You don’t know, you’re a gazelle. So you sprint away again and think you’re safe, again. Then, here come the hairless apes, slowly coming for you once again. You keep repeating this until you can’t sprint anymore. You aren’t adapted to continuously run long distances, but they are. Eventually you collapse and they get you.
That’s creepy to me. A slow moving predator who somehow always finds you and chases you until you can’t run anymore.
One of my favorite aspects about human nature is how there are things in nature that we are the best at. Sure we’re not the fastest, strongest, or most agile. But out of everything in the animal kingdom, we can run the longest.
Humans are adapted to do what very few animals can do, which is run for extended periods of time. Here’s where it gets creepy, I saw it explained like this:
Imagine you’re a gazelle on the plains of Africa early on in human history. You see some hairless apes running towards you, but f**k are they kind of slow. So your instincts kick in and you sprint away. Once they’re out of sight you relax and go back to eating grass or whatever you’re doing. But f**k, there they are again, running slowly towards you. How’d they figure out where you went?
You don’t know, you’re a gazelle. So you sprint away again and think you’re safe, again. Then, here come the hairless apes, slowly coming for you once again. You keep repeating this until you can’t sprint anymore. You aren’t adapted to continuously run long distances, but they are. Eventually you collapse and they get you.
That’s creepy to me. A slow moving predator who somehow always finds you and chases you until you can’t run anymore.
"But out of everything in the animal kingdom, we can run the longest " Good one, but I prefer "of everything in the animal kingdom, we can throw the furthest and most accurately." Our ability to throw would have quickly made us top predators.
This is all fine and good, the strange part is that many people actually enjoy the sensation of goosebumps and a heightened heart rate. It’s very human, it seems, to take a biological marker of fear and danger and turn it into entertainment. Even more weirdly, there are people who can actually induce goosebumps, and this state of tension manually, which is a good party trick, but a strange ability to have.
 After a back surgery, your organs might have been moved to perform certain parts of the surgery. The doctors don't move your organs back to their original place. This funny feeling you get after the surgery is your organs moving themselves back to their original place. Yes, they are capable of that.
After a back surgery, your organs might have been moved to perform certain parts of the surgery. The doctors don't move your organs back to their original place. This funny feeling you get after the surgery is your organs moving themselves back to their original place. Yes, they are capable of that.
 You only need 30 people in order to trigger mob mentality in order to control an entire cowed of anywhere upwards to 10,000+ people blindly copying them.
You only need 30 people in order to trigger mob mentality in order to control an entire cowed of anywhere upwards to 10,000+ people blindly copying them.
There are also sounds that create this feeling despite no good explanation for them. Nails on a chalkboard and the scraping of metal utensils on metal both have this effect on many humans, but there does not seem to be a good evolutionary explanation. Our early ancestors did not need to feel fear at wasting chalk in such a manner, so there are all sorts of wild speculation as to why we have this reaction.
 Risks during birth are abnormally high compared to other species. Because of our upright gait (mother's narrow pelvis) and big heads, fetuses cannot 'fully' gestate until being born. Humans have to be born prematurely while the head is still tiny and squishy. Otherwise, childbirth would not be survivable at all.
Risks during birth are abnormally high compared to other species. Because of our upright gait (mother's narrow pelvis) and big heads, fetuses cannot 'fully' gestate until being born. Humans have to be born prematurely while the head is still tiny and squishy. Otherwise, childbirth would not be survivable at all.
We are also the only idiots that cry right after birth, giving away the position of the mother and child to potential predators
 Because the eyes are not only incredibly vulnerable to infection due to the moisture, they're also a direct connection to our brain. This necessitates an additional layer of immune security.
A seperate immune system has several advantages. Firstly, pathogens cannot travel from the eyes to the body, or the body to the eye. You wouldn't want a stomach virus to make you go blind! A normal immune response in the eye would mean swelling, which would destroy the eye. The eye has several different layers of security specifically because they're so important.
Because the eyes are not only incredibly vulnerable to infection due to the moisture, they're also a direct connection to our brain. This necessitates an additional layer of immune security.
A seperate immune system has several advantages. Firstly, pathogens cannot travel from the eyes to the body, or the body to the eye. You wouldn't want a stomach virus to make you go blind! A normal immune response in the eye would mean swelling, which would destroy the eye. The eye has several different layers of security specifically because they're so important.
Immune privilege, your eyes won’t swell up and fill with lymph or blood during an attack from a pathogen. Your testes and ovary also have immune privilege
One possible explanation for some people’s love of horror could be that the adrenaline and intensity of the fight or flight emotion is not that far from the feelings we have when dopamine is produced in our body. Domaine, famously, feels pretty damn good, so there are people who enjoy acquiring it or “similar” experiences from other means.
 Learned memories, i.e. people 100% sure they remember things which actually never happened but were told many times by media/memes/others. I observed this for certain episode which happened less than 10 years ago and which everyone whom I asked witnessed themselves personally, but they all “clearly remember” it in a way it was presented in memes and jokes and not how they actually saw it happen.
Learned memories, i.e. people 100% sure they remember things which actually never happened but were told many times by media/memes/others. I observed this for certain episode which happened less than 10 years ago and which everyone whom I asked witnessed themselves personally, but they all “clearly remember” it in a way it was presented in memes and jokes and not how they actually saw it happen.
Human memory is super fallible. It's an unreliable witness in court proceedings.
 If you happen to have brain injury, there is a condition that makes you unable to recognize objects around you. Like, you will see a fork, the colors and the shape of it, but you can’t know how to use it, if it’s edible or not, etc. Pretty scary thing to imagine.
If you happen to have brain injury, there is a condition that makes you unable to recognize objects around you. Like, you will see a fork, the colors and the shape of it, but you can’t know how to use it, if it’s edible or not, etc. Pretty scary thing to imagine.
I recommend Oliver Sacks' books if you want to know more about neurological disorders and stories of real people living with these.
 We possess the genes for regeneration similar to starfish and salamanders. They are on the same chromosome as the genes for scar tissue formation. However they are not turned on whereas the scar tissue genes are.
So technically, we could pull a Piccolo and regenerate limbs like a starfish. But we don't because it's waaay too metabolically demanding on energy. If we could do it, you'd likely shave years off of your life in exchange. Instead we make scar tissue to reinforce the injured area.
We possess the genes for regeneration similar to starfish and salamanders. They are on the same chromosome as the genes for scar tissue formation. However they are not turned on whereas the scar tissue genes are.
So technically, we could pull a Piccolo and regenerate limbs like a starfish. But we don't because it's waaay too metabolically demanding on energy. If we could do it, you'd likely shave years off of your life in exchange. Instead we make scar tissue to reinforce the injured area.
We DO regenerate. If you are a living liver donor, they take part of it. Both the donor and the recipient will regrow the missing part and end up with a complete liver.
On a more general note, there is not actually a good reason why we call them goosebumps. Many other birds have similar skin, including the considerably more common chicken. Other mammals also have this reaction, but for some reason, in multiple languages, waterfowl of some sort are used to describe this biological reaction. For example, in Hebrew, it’s a duck, not a goose.
 Your stomach acid can dissolve a razor blade, right? Well another thing is that your stomach is constantly fighting to not get dissolved by the acid. Have a nice day :) also thank u for 257 upvotes, most ive ever gotten
Your stomach acid can dissolve a razor blade, right? Well another thing is that your stomach is constantly fighting to not get dissolved by the acid. Have a nice day :) also thank u for 257 upvotes, most ive ever gotten
Do not swallow razor blades to test this theory. A swallowed razor blade can do a lot of damage. Even more important, don't swallow safety pins that are clipped up, the stomach muscle movement is enough to unclip them.
 We do not have any undeniable way of proving that ANYTHING going on right now is real. This might all just be an illusion made by the mind. In the grand scheme of the universe, every event that led to this exact moment are all impossibly unlikely to happen, and comparatively, it's way more likely that the life we all see ourselves is a figment of a briefly lived consciousness in the endless nothingness of an empty space.
We do not have any undeniable way of proving that ANYTHING going on right now is real. This might all just be an illusion made by the mind. In the grand scheme of the universe, every event that led to this exact moment are all impossibly unlikely to happen, and comparatively, it's way more likely that the life we all see ourselves is a figment of a briefly lived consciousness in the endless nothingness of an empty space.
This idea is called the Boltzmann Brain. And it's a real thing. For "impossibly unlikely" read "incredibly unlikely", because nothing is impossible in quantum mechanics.
 We are one of the most violent things on earth, yet so social. We legit will help even our enemies when needed.
Its creepy, because we will easily team up snd go back to killing eachother.
We are one of the most violent things on earth, yet so social. We legit will help even our enemies when needed.
Its creepy, because we will easily team up snd go back to killing eachother.
The Uncanny Valley phenomenon suggests that we've had to fear something in human history that *looked* human but wasn't (Edit: I'm talking things that are ALMOST human but not quite. Corpses don't creep me out as much as duplicate horror or life-like dolls.)
It’s probably just to keep us away from really diseased people who aren’t acting right so we don’t catch it, eg rabies or something.
 There really is no profile of a person who falls victim to a cult. Anyone is susceptible. Cult members can come from any socioeconomic or educational background, any race, sex, religion.
There really is no profile of a person who falls victim to a cult. Anyone is susceptible. Cult members can come from any socioeconomic or educational background, any race, sex, religion.
Seems to me like someone who believes nothing and hates following orders might have a harder time with joining a cult. Unless its run by a very cute dog, in which case, let me gather some sticks for you oh mighty doggie overlord. Also I will give you all the belly rubs you need and donate as many tennis balls as you can chew.
We're an invasive species. By definition. > An invasive or alien species is an introduced species to an environment that becomes overpopulated and harms its new environment. Invasive species adversely affect habitats and bioregions, causing ecological, environmental, and/or economic damage. From Wikipedia. An opinion that's heavily disputed is humans are cancer. I think it's true, but this isn't officially a fact and therefore shouldn't be counted as one.
That Opinion sounds like Agent Smith from the Matrix Movies. But yeah, the Human species behaves cancerous.
 Your frontal cortex makes it breaks you via your decisions. It’s where all the critical thinking goes through the manual computer of dopamine pathways.
Ever wonder why decisions are so crazy in your dreams? Or why it ask makes a little too much sense in the moment? Frontal cortex is off during rem.
Grandma didn’t abandon having a filter with age. The decay of her frontal cortex is no longer preventing her from saying awful or embarrassing things.
Bump your head in some kind of accident? Hope it wasn’t the front, because if so your chances of committing crime just rose more than 100%
Your frontal cortex makes it breaks you via your decisions. It’s where all the critical thinking goes through the manual computer of dopamine pathways.
Ever wonder why decisions are so crazy in your dreams? Or why it ask makes a little too much sense in the moment? Frontal cortex is off during rem.
Grandma didn’t abandon having a filter with age. The decay of her frontal cortex is no longer preventing her from saying awful or embarrassing things.
Bump your head in some kind of accident? Hope it wasn’t the front, because if so your chances of committing crime just rose more than 100%
 I remember reading that if you look at pictures of sick people, your immune system will automatically give itself a little boost just by looking at the pictures
I remember reading that if you look at pictures of sick people, your immune system will automatically give itself a little boost just by looking at the pictures
 Eventually, all our graves go unattended.
Eventually, all our graves go unattended.
 How one person can rule over millions of people. 100 million humans can fear one person collectively, and that person will remain in power for years until death. Once they die, that collective fear morphs into the worshipping of that evil person.
How one person can rule over millions of people. 100 million humans can fear one person collectively, and that person will remain in power for years until death. Once they die, that collective fear morphs into the worshipping of that evil person.
Children are more or less sociopaths. We teach them empathy, kindness, and sharing. There are several psychologists that hold the belief that in a societal breakdown scenario children will actually fair better than adults once they arm themselves, because adults will have a harder time murdering another human. Meanwhile, children who's brains and emotional response centers have not fully formed will be much more able to mercilessly kill others for survival or supplies.
"sociopaths" is the wrong word here. But remember the Red Guards, Mao's army of children.
[Humans are hard wired to see faces in things](https://en.wikipedia.org/wiki/Pareidolia). It's thought it was to help us stay away from sabre toothed tigers and such, but now we see the Virgin Mary in a tomato slice.
 "Cute Aggression."
Have you ever seen a cute little puppy? or a soft fuzzy chinchilla? or a cut tiny little baby, and gotten this urge to squeeze it? The reason for this is not nearly as innocent as you might think.
It's highly speculated that the reason humans develop this urge is because our wirings do not allow us to comprehend what we are feeling when we see something "Cute" our sensors go kind of haywire, and because of this we have a subconscious urge to "Destroy" this cute entity to relieve us of the distress we are experiencing as a result of its existence.
Very dark stuff
"Cute Aggression."
Have you ever seen a cute little puppy? or a soft fuzzy chinchilla? or a cut tiny little baby, and gotten this urge to squeeze it? The reason for this is not nearly as innocent as you might think.
It's highly speculated that the reason humans develop this urge is because our wirings do not allow us to comprehend what we are feeling when we see something "Cute" our sensors go kind of haywire, and because of this we have a subconscious urge to "Destroy" this cute entity to relieve us of the distress we are experiencing as a result of its existence.
Very dark stuff
This is interesting. Grandmas telling babies they want to eat them just got more understandable.
 **Aphantasia:**
Almost 4% of people do not have visual imagination, and cannot use the "movies in the head" effect at all. Their imagination works on either language, abstracts and raw emotions or on imagining sounds and tactile input.
Imagine how absolutely creepy and alien their thoughts must be to a regular phantasic person. Their minds work more like hyper advanced ChatGPT than like those of other homo sapiens.
https://en.wikipedia.org/wiki/Aphantasia
**Aphantasia:**
Almost 4% of people do not have visual imagination, and cannot use the "movies in the head" effect at all. Their imagination works on either language, abstracts and raw emotions or on imagining sounds and tactile input.
Imagine how absolutely creepy and alien their thoughts must be to a regular phantasic person. Their minds work more like hyper advanced ChatGPT than like those of other homo sapiens.
https://en.wikipedia.org/wiki/Aphantasia
I don’t know what this is called but this is when I realised that human beings are extremely selfish. And I was equally horrible and a part of this. I was in second or third grade, around 8 years old I guess? So when school got over, it was the last day or something and all the kids in my class (about 40-50 kids) ran out the door at the same time. One of the girls in my class fell over. Kids kept trampling over her. And some of us noticed that. But if we stopped to help her or bent down, we would also get trampled over. So we just ran and left. I still feel so bad about that. Thankfully nothing happened to her and she just scraped her knees and elbow. But I feel so bad about it till today.
 On a recent date with a CSI I learned that a lot of people die naked on or near the toilet. Apparently people get very hot and try to strip down when close to death.
On a recent date with a CSI I learned that a lot of people die naked on or near the toilet. Apparently people get very hot and try to strip down when close to death.
Could it be that they're naked near the toilet because they're getting into or out of the bathtub or shower?
 If you're bored enough you will begin to intentionally hurt yourself.
If you're bored enough you will begin to intentionally hurt yourself.
 You're not as perceptive to touch as you might like to think. Particularly in areas like your back, I could poke you with two fingers inches apart and you'd think I was only used 1 finger.
You're not as perceptive to touch as you might like to think. Particularly in areas like your back, I could poke you with two fingers inches apart and you'd think I was only used 1 finger.
We all have our flaws and quirks, but there are some aspects of human behavior that are just plain creepy. Here are some creepy facts about human nature that will make you shudder: **We're drawn to the macabre:** Whether it's horror movies, true crime podcasts, or haunted houses, many people have a fascination with the darker side of life. It's thought that this interest stems from our primal need to understand and prepare for danger. **We can be cruel to animals:** While many of us love our pets and consider them part of the family, there are also people who are capable of unspeakable acts of cruelty towards animals. From puppy mills to animal testing, it's a sad fact that some humans view animals as nothing more than objects to be used and abused. **We're easily influenced by authority:** Studies like the infamous Milgram experiment have shown that humans can be easily influenced by authority figures, even if it means causing harm to others. This is a disturbing reminder of how easily we can be manipulated. **We're capable of extreme violence:** While most of us would never dream of harming another person, there are those who are capable of extreme violence. From serial killers to war crimes, it's a chilling reminder that human beings can be both the best and worst of creatures. **We're fascinated by death:** From Victorian post-mortem photography to memento mori jewelry, humans have long been fascinated by death and the macabre. While some may view this as a morbid curiosity, others see it as a way to confront and understand our own mortality. These are just a few examples of the creepy and unsettling aspects of human nature. While it's important to acknowledge and understand these darker sides of ourselves, it's also crucial to remember that the vast majority of people are good and decent. As always, it's up to us to choose which aspects of our nature we want to cultivate and which we want to overcome.
I really like the post-mortem pictures. There is a beautiful quiet calm about them that touches my soul. I've never found them macabre. Death is an inevitable part of life and it comes with bittersweet melancholy. I'm a tortured artistic soul, so that might explain it.
We create weapons and kill other humans just because we disgaree with each other.
"Disagree" is the wrong word here. "Feel threatened by" or "Feel jealous of" would be better.
Some people play sick twisted games with other people's lives .
This is so true; not me but a friend told me this. His Mom was quite the psycho. He claimed if she was mad at one of her boyfriends she would really talk them up and get them in a good mood, then get them drunk so the point memory was suspect. She would then pick a fight which usually ended with them just going outside to get away from her. She would then get in her car and go brush them just enough to cause minor injuries. She would then load them up and go to the ER where she would present this as, "he got drunk and I tried to stop him from getting into trouble and he ran into my car." He claimed she did this to build the case in the future that the person was a troublesome drunk if they got violent and she was the innocent victim.
 The eyes have a separate immune system than the rest of the body. If your body's immune system realizes your eyes exist, it'll attack the eyes and reject them from the body as it would a virus.
The eyes have a separate immune system than the rest of the body. If your body's immune system realizes your eyes exist, it'll attack the eyes and reject them from the body as it would a virus.
Why is that creepy? Also brain and testes have this "immune privilege", and the same for fetus and placenta. It only means that such organs have different immune responses than the rest of the body.
Bacteria dictates our behaviour.
Bacteria dictates our behaviour.
Intestinal bacteria have been studied and it has been found that an imbalance causes, for example, depression. I haven't read enough to provide more examples or links to studies.
 You want a weird design flaw? Our retinas are backwards. Meaning our cones and rods (cells that react to light) point to the back of the eye.
This is evident by the blind spots everyone has which are basically the optic nerve going from inside the eye through the retina and then out to the brain.
You want a weird design flaw? Our retinas are backwards. Meaning our cones and rods (cells that react to light) point to the back of the eye.
This is evident by the blind spots everyone has which are basically the optic nerve going from inside the eye through the retina and then out to the brain.
It's not a design flaw. It prevents the receptors from being overly stimulated due to light touching them directly if it were built they other way around.
You don’t need to have 2 eyes to have *some* depth perception. Close one eye and look at something close and then something far away. You can still tell which is closer, even if it’s unfamiliar. That’s because there’s a feedback loop between your brain and the nerves that stretch your eye lens to focus images.
It's also one of the many reasons that VR headsets can give you a headache/nausea/eye strain/disorientation/etc. as there's a disconnect between the apparent distance of objects and the point in space that your eye is actually focused on - one part of your visual system is saying "that object is close, that object is far away" due to the stereoscopic separation and another part is saying "they're both the same distance away" because your eye is actually focusing on the screen.
Sometimes, real every day human beings (you won't f*****g believe this!) copy old posts off of reddit and repost them.
You aren't you. What you see when you look in the mirror is just a protective casing created by your parents mixing their dna together. What you are is actually just your brain, eyes and nervous system. And if you want to get more into it, your thoughts are just your brain dictating what it thinks is right/wrong in-order to keep itself alive for as long as possible
We think with our emotions more than logic
We think most with our "zombie", that controller of unconscious actions that never reach the conscious mind. This is not the same as being controlled by our Id / emotions.
The reason you close your eyes when you sneeze is because your body is making sure you don't blow them put of your head
False. The reason is so that you don’t get the stuff you sneezed out in your eyes
Humans learn by mimicking
We don't exactly descend from the Homo sapiens. Most people believe that the Homo sapiens evolved into what we are now, the Homo sapiens sapiens, but that's not true for EVERYONE. When the Sapiens migrated from Africa to Europe, there still were Neanderthal around, and in that occasion the two species mixed (some scientist believe that Neanderthal men raped Sapiens women). A small percentage of Europeans and Asians (1.7% circa) has direct Neanderthal ancestors. Fun fact: a gene involved in Covid19 resistance is directly correlated to the Neanderthal genome. This means that the 1.7% of the population who has some remaining of Neanderthal genes is less susceptible to infection and/or death via Covid19.
No, you've got the right idea but you've got that back to front. Instead of "a small percentage of Europeans and Asians (1.7% circa) has direct Neanderthal ancestors" it's most Europeans and Asians that have Neanderthal heritage, and many Polynesians and some other people have Denisovan heritage. We're all descended from Homo Sapiens, but most of us have up to 1.7% Neanderthal heritage as well. As a side note, the people with the highest proportion of Neanderthal genes (myself included) come from an area that maps directly onto a people called the Anglo-Saxons. So if you see someone boasting of their Anglo-Saxon heritage, think Neanderthal.
We were all narcissists once.
Sociopath just lack the empathy. People who are normal have empathy, but they have all the traits of Sociopath too. In fact, our empathy can drive a normal person to commit horrible crimes. Properly motivatef, our emotions can cause us to do things much worse the sociopath. Kick someone dog. Also their kid. Punch their grandmother. Do those things, and see people become something to fear.
We think we are 90% rational and 10% emotional, but it's the opposite.
I like the thought, but I disagree that it can be measured so precisely for every person in every situation.
look up bystander effect and mob mentality, there's another one I forget the name of as well that's similar where people will do terrible things they are not comfortable with when a person in authority is giving them orders/saying it's ok. It's scary how easy it is for good people to do terrible things or ignore terrible situations they have the convenient power to fix.
Yes. Look up Milgram Experiment. "The Milgram experiment is a famous psychological study exploring the willingness of individuals to follow the orders of authorities when those orders conflict with the individual's own moral judgment."
there’s another comment on here about internal voice - about that… From my experience, I’ve noticed that people who think mostly visually/emotionally and people who think by mostly talking to themselves and questioning everything do not have a very good chance of understanding each other and one person might get sick of the other one because of how they think or how they like to have conversations (ex, someone who likes to ask lots of questions vs. someone who wants to get the idea across with as little thought as possible) My example isn’t the best, but i’ve had conversations about this with people, and as a person who thinks mostly visually - there are people who cannot understand why or how I think the way I do. EDIT: i’m starting to wonder if having a different way of thinking leads into being introverted/extroverted? ex. Visual = wanting to be blunt, might tie into not wanting to talk to anyone in fear of having to carry on a whole conversation.
Rounded to a whole number, the average person has one testicle and one ovary
And one eye, and one arm, and one leg, and one lung, and one kidney, etc. etc.
Human babies were designed to be cute so we don’t eat them
Human babies aren't cute. Puppies are cute, kittens are cute, almost all baby animals are cute. But not human babies, they're ugly red wrinkly messes that scream a lot.
It's not necessarily as creepy as it is sad but it's surprisingly common to hear of men's last words before a semi-spontaneous death being a cry out for their mother.
The way we decompose into the earth to give back to Mother Nature. Decomposition is so interesting in dead bodies.
Some parasites make humans more attractive so they can pass on their parasites to the next person. Like bacteria, parasites can alter our behaviors to be attractive and sociable to spread the parasites to others. Unlike bacteria or sudden infections that alter our behaviors momentarily, parasites sit dormant in our bodies and it lives with us for all our lives, secretly pulling the strings.
People are terrible at associating cause and effect, especially in their own thoughts. There was a study done where parents of unruly children were wired up to study the physiology of getting angry. Parents would of course frequently get angry and explain that the child did something that caused their anger. The actual brain activity and stress responses almost always started long before the child's behavior the parents associated as the cause. People get emotional reactions to internal things mostly, like our blood sugar levels changing. We usually blame them on external events though.
The more people there is to witness a violent scene, such as a seeing a homeless person beging, sexual agression, fight or even murder, the less people tends to intervene to stop it. It is called the bystander effect, the more people there is, the more they're inhibited to feel guilty in not acting towards the violent scene. [One of its infamous victim is Kitty Genovese, that was murdered in front of 38 persons that never took action to help her. ](https://en.m.wikipedia.org/wiki/Murder_of_Kitty_Genovese)
This one is a bit dubious though. The Kitty Genovese case which led to the bystander effect being proposed is very misleading. One of the major newspapers at the time published a massively misleading story, which then got picked up by others and became "fact". In reality the number of "witnesses" was far fewer, most could not see the crime scene from where they were, and people did try to help and called police. A study in 2019 using real life examples on security cameras found that in most cases bystanders would help, and the chance of bystanders intervening increased with the number of bystanders present
I remember reading an article somewhere that states a person has a “voice” that they can hear, I guess like an internal monologue or something along those lines. And another that is screaming at them, but we cannot hear it. This was probably a 3am, can’t sleep article so it may just be junk. But maybe someone knows what I’m talking about? Edit: Was cooking dinner when I posted this so I didn’t proof read it, sorry about that. What I meant when I said we “cannot hear” it, I meant it’s like a voice deep in our sub conscious that’s left over from the time where humanity was more primitive. It’s a part of our psyche that we’ve buried, but it’s still faintly there. Again, I don’t remember all the details and it’s probably exaggerated.
 We do not hibernate
We do not hibernate
The only thing we have to do is die. Everything else is a choice.
Our minds are different but due to our "human nature" are vulnerable to act in similar ways in similar situations. Rapes, molestation, genocides and all manner of evil things can be done by people mentally similar to you. Stanley Milgram demonstrated this: https://en.m.wikipedia.org/wiki/Milgram_experiment He was asking questions how something like the Holocaust could have happened and this is the disturbing human nature answer.
Not really creepy, but it’s in our nature to be violent. I believe it’s because we simply just get bored
There's a Thurber cartoon that says "bored ponies develop troublesome vices". To some extent this is true of humans as well. But on the other hand, if human ancestors had no free time to experiment then we could never have developed civilization.
Cosmic rays can cause mutations on the human body.
Lots of things are more effective at causing mutations in the human body than cosmic rays. Retroviruses for example. And sunlight. And there are also plenty of mutations without cause.
Researches determined that out of every 1,000,000 people approx 1-2 will die while or from pleasuring themselves.
The fact that the "uncanny valley" exists hints that there was something in our evolutionary past that looked very much like us, but was dangerous
Less than 100 years from your death no one will remember you
Depends on your actions I would say, somebody like Bundy or Dahmer probably will be remembered for a long time
If you put multiple random people annonymous (mask or smth) in a room and let them controll someones life (one good one bad option in every situation) the persone will ultimitly die earlier. [The Experiment Show with Derren Brown: Remote Controll] Sry about the Grammar.
When a human die in the ocean their body will be eating by crabs and others creatures… then people eat crabs ( and other see food who ate the human dead body) … that’s the real endless cicle
Let's for a moment pretend I'm not going to be eaten by my cats, and am buried in the ground in a timely manner. Decomposition aided by insects > Insects eaten by birds > bird eaten by cats (damn I knew they'd still get me).
Everyone lives and behaves for an audience. It wasn’t that long ago when humans would pillage, rape and murder for power and resources. We are fooling ourselves by living in humane society. We are but apes and capable of worse evil and carnage than any animal because we can lie, hide and cheat to pretend we’re noble, moral and capable of living in society.
Is it truly a human nature though? Or do people who write such things harbor some unsavory desires and assume everyone is like that so they can feel better about it?
we are exactly how Mother Earth made this small part of her skin. We behave a lot like white blood cells with our us/them
We are an extreme anomaly. We don’t belong in this Universe.
But we're part of this Universe - Every atom of oxygen in our lungs, of carbon in our muscles, of calcium in our bones, of iron in our blood - was created inside a star before Earth was born.
This thread is ok, but be warned - it's vaguely depressing and very repetitive. Also it repeats itself a lot. You will read the same thing written in subtlety different ways many times. Prepare yourself for that repetition is what I'm saying.
Here's another one, "Humans are meeeeaaan and it's in their natuuuure," written by someone who lives in a civilized society, probably from their couch, on their computer designed by humans to allow us to educate ourselves and share things, most likely in good health thanks to medicine (also created by humans to heal and live longer lives), and who has probably never experienced war or extreme danger in their life. Just trying to act edgy. lol
This thread is ok, but be warned - it's vaguely depressing and very repetitive. Also it repeats itself a lot. You will read the same thing written in subtlety different ways many times. Prepare yourself for that repetition is what I'm saying.
Here's another one, "Humans are meeeeaaan and it's in their natuuuure," written by someone who lives in a civilized society, probably from their couch, on their computer designed by humans to allow us to educate ourselves and share things, most likely in good health thanks to medicine (also created by humans to heal and live longer lives), and who has probably never experienced war or extreme danger in their life. Just trying to act edgy. lol

 Dark Mode
Dark Mode 

 No fees, cancel anytime
No fees, cancel anytime 















































